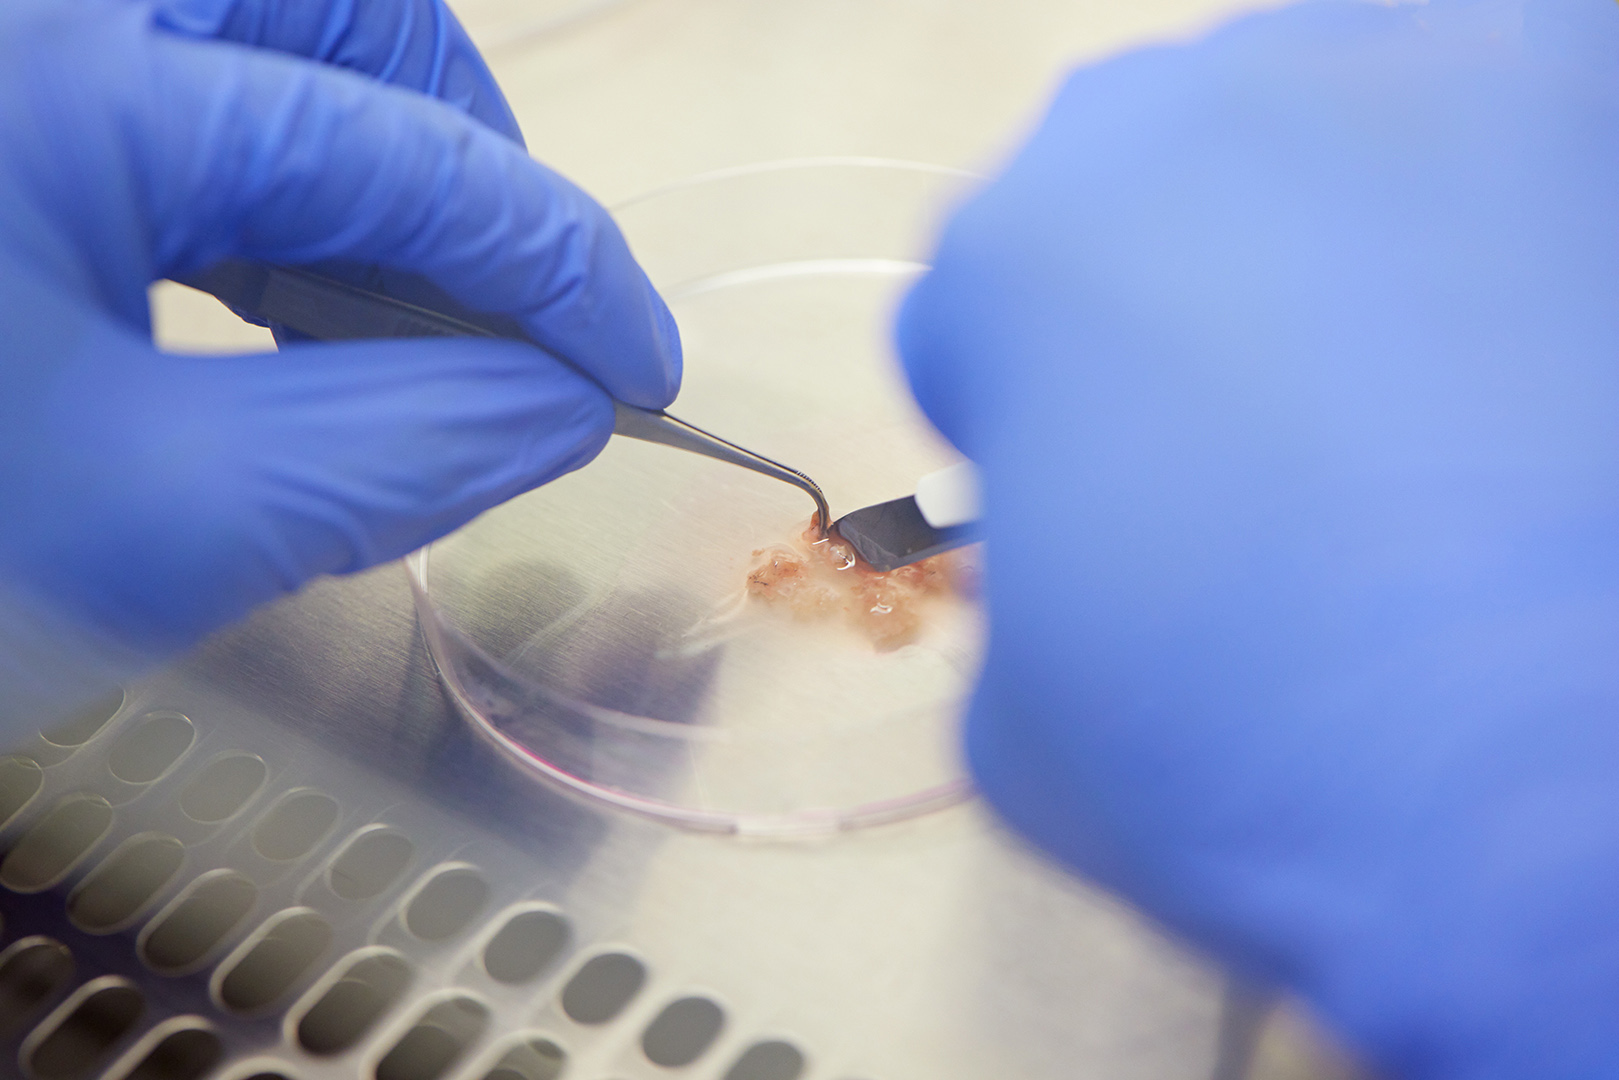
copyright Maurice Haas - Roche – Celebrate Life

©Lucas Ziegler
Maurice Haas has a stunning gift for portraying people and grasping each person’s character in a minimum of time. His subtle orchestration of light and environment accentuates characteristic traits and gives a fine impression of the pictured person’s nature. Because of this gift Maurice is very much in demand as a photographer of celebrities. Another forte of Maurice’s is his eye for reportage and details—whether he visits a luxury shoe manufacturer in Italy or the exquisite castle of design guru Axel Vervoordt in Belgium: He always comes back with photographs full of atmosphere and beauty.
Maurice Haas lives and works in Zurich.
Editorial
AD Architectural Digest
Annabelle
Another Magazine
Bilanz
Bolero
Citizen K
Curve Magazine (Australia)
Das Magazin
Der Spiegel
Ferrari Magazine
Friday
Glamour (France)
GQ (Germany)
How to Spend It (FT UK)
Internazionale (Italy)
Manager Magazin (Germany)
Optimum (France)
SZ MAGAZIN
Swiss Magazine
Wallpaper*
ZEIT Magazin
Commercial
Audi AMAG
AXA Versicherungen
Basellandschaftliche Kantonalbank
Bâloise Versicherung
Bundesamt für Kultur
Coop Schweiz
Credit Suisse
Dallmayr
Helvetia Versicherung
IWC
Kjus
LGT
Maison Gassmann
Migros
Mobiliar Versicherung
Nestlé Nespresso
NZZ
Piaget
Sanitas
Santoni
Schweiz Tourismus
Schwyzer Kantonalbank
Swisscanto
Swisscom
SwissLife
UBS
VBZ
VP-Bank
Ypsomed
Zai Ski
Zimmerli of Switzerland

